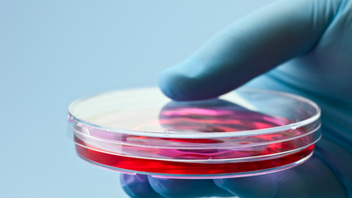

top of page



O que perguntar sobre os tratamentos com células tronco?
Existem certas informações que você deve verificar se estiver considerando um tratamento com células-tronco, incluindo uma descrição...

Socell
23 de jun. de 20233 min de leitura


Ficha técnica de doenças
A pesquisa com células-tronco é uma grande promessa para os tratamentos médicos, mas os cientistas ainda têm muito a descobrir sobre como...

Socell
23 de jun. de 20231 min de leitura


O que são células tronco?
São tipos de células que podem se diferenciar por serem células com funções muito especializadas, constituindo diferentes tipos de...

Socell
23 de jun. de 20231 min de leitura

Quais são os tipos de células tronco?
São três os principais tipos de células tronco, as células tronco embrionárias e as adultas (encontradas principalmente na medula óssea e...

Socell
23 de jun. de 20232 min de leitura


Como as células tronco podem ser utilizadas
As células tronco podem ser utilizadas no tratamento de diversas doenças, já que possuem a capacidade de autorrenovação e diferenciação,...

Socell
23 de jun. de 20232 min de leitura


Lei de Biossegurança no Brasil
Com a aprovação da Lei de Biossegurança (LEI 11.105/2005) a realização de pesquisas com células tronco embrionárias passa a ser permitida...

Socell
23 de jun. de 20231 min de leitura


Covid 19: Terapia com células tronco dobra chance de sobrevivência
CORREIO BRASILIENSE postado em 09/06/2021 06:00 / atualizado em 09/06/2021 07:33 O efeito é observado em estudo com 40 pacientes de covid...

Socell
23 de jun. de 20231 min de leitura
bottom of page
